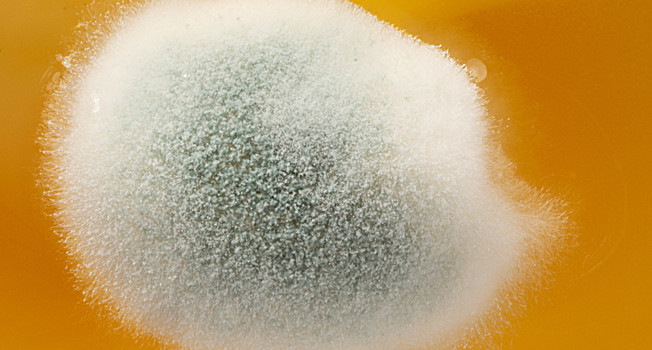
Какую плесень можно есть фото

Какую плесень можно есть
- Сергей Леонтьев
Скорее всего, каждый из нас хоть раз ел плесень. Плесень, облагораживающую сыры — как снаружи, так и внутри. И плесень, пробравшуюся в банку с заветным вареньем: выкидывать жалко, подцепил ложкой испорченный островок, выкинул — и ешь остальное.
Кто-то считает, что любая плесень опасна, и старается не допускать ее употребления. Кто-то ссылается на советские времена и, отрезав от батона испорченную корочку, пускает хлеб в оборот.
Мы решили напомнить согражданам правила общения с плесенью, для чего поговорили с Натальей Рамазановной Ефимочкиной, ведущим научным сотрудником лаборатории биобезопасности и анализа нутримикробиома ФГБУН «ФИЦ питания и биотехнологии».
«Совершенно спокойно можно употреблять в пищу те продукты, в которых плесень присутствует намеренно. Самый популярный пример — это продукты, которые с помощью плесени вырабатываются. В первую очередь это сыры, и их принято делить на две категории. Первая — это сыры, вызревающие под белой плесенью, тут самые популярные примеры — камамбер и бри. Вторая — сыры с голубой плесенью вроде рокфора, которым плесень вводится внутрь, и таким образом она способствует его созреванию. Это разные плесени, среди них преобладают представители рода пеницилл, и они так и называются — пенициллиум рокфорти и пенициллиум камамберти. Есть и другие, которые встречаются реже. Все они выглядят по-разному и по-разному работают. Все они подобраны специально и, прежде чем используются, очень тщательно изучаются, чтобы убедиться в их безопасности.
То же можно говорить о плесени, которой покрывают поверхности сырокопченых или сыровяленых колбас. Эта плесень защищает продукт от высыхания и от каких-то дополнительных видов порчи. Есть ее можно смело, правда, зачастую она бывает довольно жесткой. То же касается и других продуктов, которых плесенью снабдили сознательно.
***
Теперь речь о плесени, которая появляется сама и заражает продукты как ей вздумается. Плесени бывают разные, опасные и нет, и пока вы не отнесли зараженный продукт в лабораторию, вы не узнаете, какого рода плесень он содержит. Главный риск, с которым сталкивается человек, — попадание в продукт токсигенных плесеней. Они широко распространены в природе. Микотоксины, выделяемые этими микроорганизмами, обладают специфическим неблагоприятным действием. Они вряд ли приведут к каким-то заметным резким острым отравлениям при однократном употреблении , но при постоянном поступлении в малых дозах обладают гепатотоксическим, нефротоксическим или канцерогенным действием. Хроническое поступление микотоксинов в организм считается серьезным риском для здоровья.
Поэтому очень важно контролировать качество тех продуктов, которые мы употребляем, и обращать внимание на всевозможные признаки порчи. Первый и самый очевидный признак — образование плесени на поверхности продукта. Мы рекомендуем не есть такую еду, потому что потребитель не может оценить глубину проникновения плесени и выделяемых ею токсинов в продукт. Вот несколько популярных примеров из бытовой жизни.
Например, ягоды и фрукты. Любые признаки порчи, будь то размягчение или изменение цвета, скорее всего, говорит о поражении плесенью (или бактериями). Не стоит ждать, пока ягоды опушатся плесенью и это станет всем очевидно, отложите мятую и испорченную ягоду в сторону. Не надейтесь на термическую обработку — она не приводит к уничтожению микотоксинов, многие из них не реагируют на варку и повышенную температуру. То же касается и сухофруктов. Если они изготовлены из испорченных абрикосов, слив и других фруктов, то токсины благополучно переживут сушку и сохранятся в сухом продукте.
Не стоит есть хлеб, если в одном конце батона видна плесень, а в другом — еще нет. Скорее всего, она там тоже уже есть, просто пока не видна невооруженному глазу. Если плесневые колонии появились на одной стороне продукта, это значит, что через какое-то время все то же самое можно будет увидеть и с другой стороны. Споры плесени легко отрываются от своих стебельков и основы (мицелия) и пересыпаются на другие поверхности, образуя новые колонии.
Если мы видим локальное заражение плесенью варенья в банке, то также нужно понимать: эта плесень может прорасти глубже и продуцировать микотоксины. Если варенье жидкое, лучше не рисковать и сразу избавиться от банки. Если варенье плотное, сахаристое, с текстурой джема, то теоретически можно попытаться его спасти — для этого его нужно избавить от плесени, а также убрать все, что примыкало к ней, — сантиметра четыре, не меньше. Но лучше не рисковать.
Также с повышенным вниманием относитесь к старой чайной заварке. Долго ее хранить нельзя, в ней быстро заводится плесень, которую разглядеть не всегда удается.
Помимо того, что нужно очень тщательно выбирать продукты, их еще нужно правильно хранить. Очень многое зависит от условий хранения. Часто бывает, что отделения в шкафу уже заражены плесенью. Сколько туда не помещай хлеб или наисвежайшие продукты, они все время будут загрязняться. И если там что-то залежалось и расцвело всеми цветами плесени, то нужно очень тщательно удалить колонию и промыть поверхности, особенно пористые ее части. Достаточно обработать все это мыльным раствором с содой и тщательно высушить. То же самое относится и к холодильникам: часто созданные в нем условия способствуют прорастанию и проживанию плесени. Иногда ее не видно, но она может загрязнять продукты, особенно в тех случаях, когда они хранятся в открытой упаковке. Повторю: минимальные единичные случаи употребления в пищу плесеней не опасны, но если такое происходит часто, то повышается риск нанести вред здоровью, заполучив микотоксикоз. Так что чем аккуратнее мы относимся к продукции, тем лучше.
Мы постоянно проводим исследования, которые показывают, что, помимо известных и изученных нами токсинов, существуют малоизученные микотоксины, которые раньше не обнаруживали. Они стали идентифицироваться после того, как появились чувствительные методы исследования. Так вот эти микотоксины могут загрязнять такие виды продуктов, которые раньше не связывались с рисками заражений. Поэтому наша рекомендация такова: лучше не рисковать, правильно хранить и не употреблять в пищу те продукты, качество которых вызывает сомнение.





